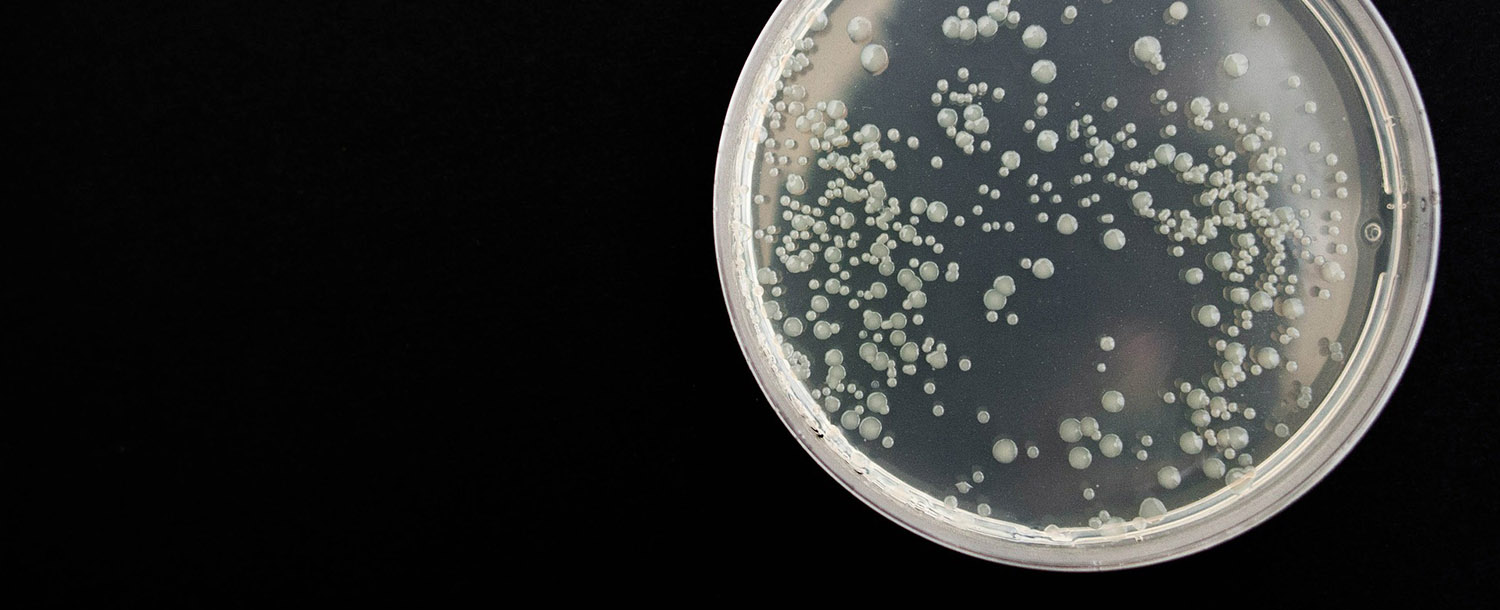

Microbial Volatile Organic Compounds (MVOCs) are produced by micro-organisms such as moulds and fungi during metabolism, which occurs during active growth in the presence of moisture and nutrients. Mould can be found in many types of building materials (wood, wall paper, plaster, cellulose) and their emissions are responsible for some characteristic musty and mouldy odours.
Typically, a musty and earthy odour is the first sign of microbial activity. The microbial activities usually result in the decomposition of complex organic compounds into simpler compounds, and, in so doing, producing a wide range of by-products including the MVOCs. Some of these compounds are unique to micro-organisms; some can be the natural components of building materials that they grow on; and others are the same as common indoor air pollutants. The microbial volatile organics are so diverse that they encompass many chemical classes. In addition, there is no fixed MVOC pattern as the microbial emissions are different depending on the specific species, the substrates and the environment. Determination of MVOCs is a useful way to check for the presence of mould. In many situations where spores of the micro-organisms are absent, the presence of unique MVOCs can be used to indicate the microbial activities.
Air quality investigation of MVOC’s allows detection of mould growth before it can be visually observed, since these compounds can easily diffuse through wallpaper and crevices from wall barriers and enclosures. Unique MVOCs consist of many different compounds that include a number of alcohols, ketones, aldehydes, terpenes, nitrogen-containing compounds and organic sulphides, which as a whole, are not common in indoor air. Since some of MVOCs have very low odour thresholds, they can easily be perceived olfactorily and consequently causing an alert of mould.
The symptoms of MVOC exposure include irritation of the eyes and respiratory tract (nasal congestion, sore throat). Individuals with asthma and allergies are more susceptible to the health effects of mould growth. Microbial emissions contribute to the Sick Building Syndrome (SBS), which is experienced by occupants in air tight and damp indoor environments.
Thermal Desorption Tubes,
Quantitative Target List
CASSEN has also developed a unique list of 40 other MVOCs which are indicators of microbial growth.